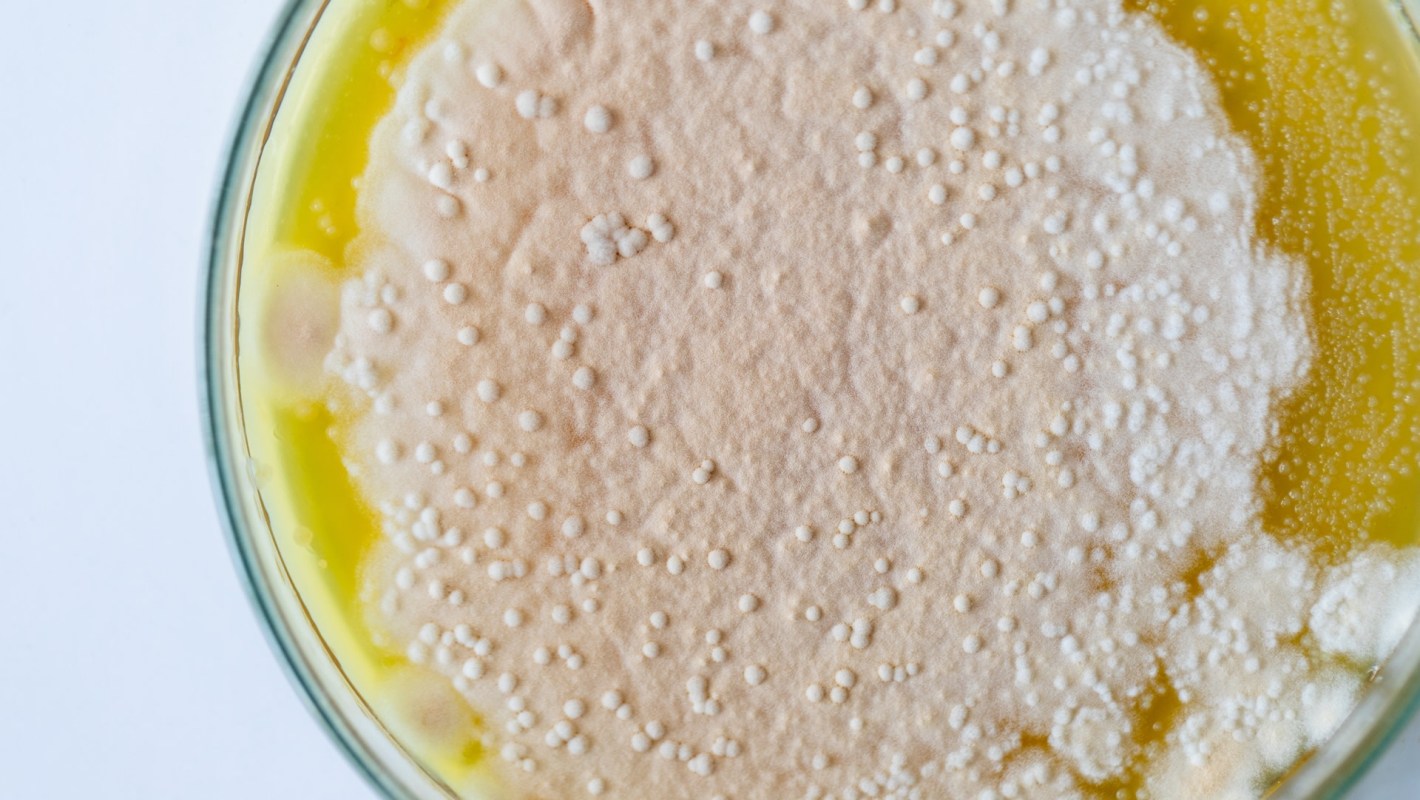

Great recipes rely on the right mix of ingredients — and scientists at Osaka Metropolitan University may have just found one that could change how we make everyday goods.
In a study published in Biotechnology for Biofuels and Bioproducts, researchers engineered a strain of yeast to convert methanol — a low-cost, renewable carbon source — into D-lactic acid.
It's a valuable ingredient that helps biodegradable plastics become stronger and more heat-resistant.
Here's the kicker: D-lactic acid is hard to produce efficiently. Most bacteria naturally make L-lactic acid, and traditional chemical methods tend to make a mix of both, which is expensive and time-consuming to separate. This yeast-based method avoids that problem and boosts yield by 1.5 times compared to earlier attempts, and it does so using just methanol.
That's a big deal for anyone who wants affordable alternatives to petroleum-based plastics.
"Our engineered yeast achieved the highest-ever reported yield using methanol as the sole carbon source," lead researcher Ryosuke Yamada said.
To make it work, the team used a yeast strain called Komagataella phaffii, known for thriving on methanol. They tested five types of a key enzyme and paired them with eight genetic switches to find the most productive combo.
Think of it like perfecting a sourdough starter, but for a material that could change manufacturing.
If this approach scales up, it could make everyday products like food containers and medical supplies cleaner, cheaper, and easier to produce.
That means more options for people looking to cut down on waste without paying more.
|
Which of these factors would most effectively motivate you to buy a refillable product?
Click your choice to see results and speak your mind. |
Since methanol can be made from renewable materials, this method supports a circular economy, a system where things get reused instead of trashed.
That's good news for your health and for the environment, since it helps keep toxic plastic waste out of our water, soil, and food.
Less plastic trash also means lower exposure to microplastics and harmful chemicals that have been linked to long-term health concerns.
There are already signs of this shift. Companies are rethinking everything from grocery bags to glitter, and services like Trashie are helping people turn old clothes into something useful instead of landfill clutter.
These efforts reduce the waste that pollutes our oceans and land, while giving everyday items a second life, often with built-in savings.
Cleaner production methods like this make it easier to live sustainably. If you're looking for a way to cut plastic from your life today, swapping in plastic-free alternatives for everyday products is a great first step.
While this new yeast-powered method is still in early stages, researchers hope we'll see it show up in real-world products, like packaging and medical tools, within the next few years.
If that happens, it's one more ingredient in the recipe for a cleaner, healthier, and more affordable future.
Join our free newsletter for weekly updates on the latest innovations improving our lives and shaping our future, and don't miss this cool list of easy ways to help yourself while helping the planet.